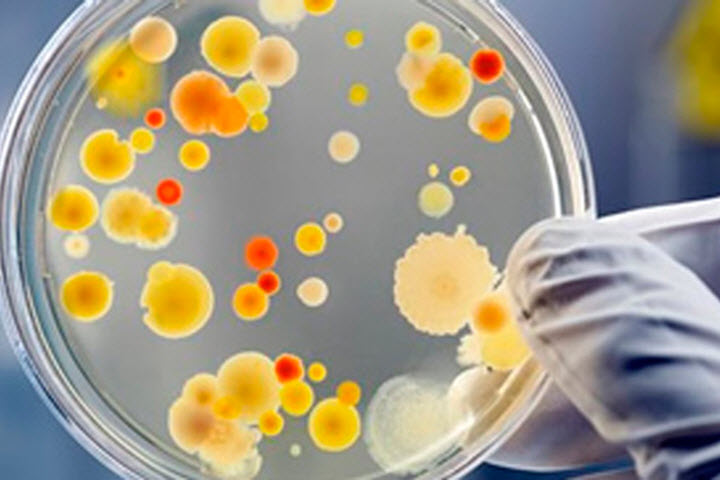
Вирус мененигита

Менингит является инфекционным заболеванием, которое основано на воспалительном процессе в спинном и головном мозге. Возбудителями недуга считаются разные вирусы и бактерии. Первые признаки менингита проявляются либо молниеносно, либо спустя пару дней после заражения. Поэтому всем людям рекомендуется изучить и запомнить основные симптомы менингита.
Что собой представляет заболевание?
Как уже сказано выше, при менингите воспаление распространяется на мозг и его оболочки. Это говорит о том, что повреждаются не мозговые клетки, а наружная оболочка, где скапливается гной.
Менингит может иметь две формы течения:
- Первичная. Здесь наблюдается единичное поражение мозга.
- Вторичная. Эта форма развивается в результате основного заболевания, которое привело к поражению мозговой оболочки. Сюда можно отнести отит, паротит и лептоспироз.
Зачастую менингит развивается стремительно. Исключением является туберкулезный его тип, который протекает несколько дольше. Рекомендуется знать все о менингите.
От болезни страдают люди всех возрастов. Основным фактором, который влияет на заболевание, считается состояние здоровья человека. Например, если ребенок рождается недоношенным, то его иммунитет сильно ослаблен, поэтому есть большой риск заразиться болезнью.
Кроме того, есть отдельные лица, которые склонны к тому, что у них появится менингит. Это люди с проблемами центральной нервной системы, с травмами спины и головы. Болезнь может передаваться от больной матери к ребенку во время родов, через еду и воду, по слизистым оболочкам, от насекомых и воздушно-капельным путем. Заболеть можно, где угодно.
Врачи отмечают, что менингит может проявляться различными симптомами, которые важно распознать на ранних стадиях. Одним из основных признаков является сильная головная боль, которая часто описывается как невыносимая. Также пациенты могут испытывать ригидность шеи, что затрудняет наклон головы вперед. Высокая температура и озноб являются частыми спутниками заболевания. Врачи подчеркивают, что у некоторых пациентов могут наблюдаться изменения в сознании, такие как спутанность или сонливость. Нередко возникают тошнота и рвота, что также должно насторожить. Важно помнить, что при появлении этих симптомов необходимо незамедлительно обратиться за медицинской помощью, так как менингит требует срочного лечения.

Какие имеются виды болезни?
Существует несколько типов рассматриваемого заболевания:
- Менингит, возникший в результате попадания в организм гемофильной палочки. Этот вариант недуга чаще диагностируют в детском возрасте. Появляется он после пневмонии, отита, сахарного диабета, травмы черепа, синусита. У взрослых симптоматика менингита может объявляться на фоне длительного приема алкоголя.
- Менингококковая форма протекает довольно сложно. Она приводит к сыпи или пятнам, которые группируются на нижних конечностях, ягодицах и слизистых оболочках, в результате чего больного то знобит, то бросает в жар, возможна рвота.
- Пневмококковый менингит встречается чаще всех остальных типов и сочетается с пневмонией. Самые большие страдания испытывают диабетики, люди, болеющие циррозом печени и алкоголизмом.
К симптомам этого варианта болезни относят поражение нервов, проблемы со зрением, приступы эпилепсии.
Если говорить об осложнениях, то бактериальный недуг часто провоцирует возникновение шока, эндокардита, гнойного артрита, плохой свертываемости крови, пневмонии, электролитных расстройств. Вирусные виды менингита проявляются лихорадочным состоянием, болями в голове и общей слабостью в теле. Туберкулезная форма считается первым симптомом туберкулеза. Ее сложно вылечить, поэтому она может привести к смерти пациента. Начинается она с температуры, головных болей и рвоты.
При любом типе рассматриваемой болезни характерно наличие менингеального синдрома – скачка внутричерепного давления. Его сопровождают сильная боль в голове, давящее ощущение на шею и уши, чувствительность к свету и резким звукам, рвота, сыпь или эпилепсия.
Первые симптомы менингита достаточно ощутимы, поэтому при их проявлении следует немедленно обратиться за врачебной помощью.
Почему возникает менингит?
Зачастую недуг провоцируют бактерии или вирусы, которые негативно влияют на мозговую оболочку и цереброспинальные жидкости. Ребенок может заразиться энтеровирусом через еду, одежду и различные предметы обихода. Взрослые чаще страдают от бактериальной формы заболевания, которую провоцируют некоторые типы бактерий. Они не вызывают менингит, пока находятся на слизистых оболочках. Если же они проникают в кровь, то воспаления не избежать.
Стрептококки группы В – еще одна причина. Эти бактерии виноваты в болезнях новорожденных, которые заразились во время или после родов.
Помимо всего прочего, есть еще некоторые причины заболевания:
- Химическое раздражение.
- Аллергия на медикаменты.
- Наличие грибка или паразитов.
- Онкологический процесс.
- Осложнения после операции на мозг или шею.
- Шунтирование по причине гидроцефалии.
- Сахарный диабет.
- Прием лекарств, которые убивают иммунитет.
- Чирий на лице.
- Анемия.
К вирусам, которые провоцируют болезнь менингит, можно отнести следующие:
- Энтеровирус, вызванный сальмонеллами, кишечными или синегнойными палочками.
- Стафилококк, который считается следствием хронических пневмоний, абсцессов, остеомиелита и сепсиса.
- Герпес. Данный вирус вызывает и генитальный герпес. Но стоит учесть, что человек, страдающий герпесом, не обязательно заболеет менингитом.
- Туберкулезная палочка. На начальной стадии болезни туберкулез наблюдается в легких или лимфатических узлах внутри груди.
- Паротит или ВИЧ.
- Вирус Западного Нила, который передается от комаров.
Это еще не все причины менингита, от которых может пострадать человек. Нужно очень внимательно следить за своим здоровьем.
Менингит — это серьезное воспаление оболочек головного и спинного мозга, и его симптомы могут варьироваться в зависимости от причины заболевания. Многие люди отмечают, что одним из первых признаков является сильная головная боль, которая не проходит даже после приема обезболивающих. Часто сопровождается высокой температурой и ознобом. Некоторые пациенты упоминают о рвоте и чувствительности к свету, что делает пребывание в ярко освещенных помещениях невыносимым. Также распространены жалобы на жесткость шеи, что затрудняет наклон головы вперед. Важно помнить, что при появлении этих симптомов необходимо срочно обратиться к врачу, так как менингит может привести к серьезным осложнениям. Люди, столкнувшиеся с этой болезнью, подчеркивают важность ранней диагностики и лечения.

Как проявляется заболевание?
Менингит – очень серьезная и страшная болезнь, ибо последствия могут быть трагическими. Это говорит о том, что всем рекомендуется знать, что такое менингит, его симптомы и лечение.
Основная симптоматика такова:
- Сильная интоксикация.
- Повышение температуры тела.
- Синюшность кожи.
- Болезненные ощущения в мышцах и суставах.
- Проблемы с дыханием и пульсом.
- Посинение треугольника над губами.
- Понижение давления.
- Потеря аппетита.
- Постоянная жажда. Если человек прекращает пить воду, то это можно расценить как очень плохой симптом.
У маленьких детей менингит можно распознать по следующим признакам:
- Повышенное возбуждение.
- Беспокойство.
- Вскрикивания.
- Диарея.
- Сонливость.
- Частое срыгивание.
- Периодически повторяющиеся судороги.
Примечателен тот факт, что человек старается избегать света: он с головой накрывается одеялом и отворачивается к стене. Кроме того, есть один проверенный способ определения заболевания: положить больного на спину и прислонить подбородок к груди. Если его ноги согнулись сами по себе, то это менингит.
Какие признаки менингита наблюдаются с первых часов болезни? Вот некоторые из них:
- Ригидность мышц на затылке. Человеку сложно согнуть голову. Через какое-то время данное движение и вовсе становится не доступным.
- Симптом Кернига, проявляющийся тем, что ноги, согнутые в коленях, не разгибаются.
- Симптом Брудзинского. Если больному надавить на лонное сочленение, то его ноги согнутся непроизвольно.
- Симптом Лесажа. Если у ребенка набух, напряжен или пульсирует родничок, то это может быть проявлением менингита.
Еще один метод проверки: взять малыша под мышки и наблюдать за его головой. Если она закинута, а ноги подтянуты, то менингит налицо. - Симптом Бехтерева, в процессе которого сокращается мимика при легком прикасании к скулам.
- Симптом Пулатова основан на появлении болевых ощущений при постукивании по черепу пациента.
- Симптом Менделя – болезненность при прикосновении к ушам.
Если воспаление затронуло черепно-мозговой нерв, то возможна такая клиническая картина:
- Проблемы со зрением.
- Двоение в глазах.
- Косоглазие.
- Парез мимических мускул.
- Ухудшение слуха.
- Спутанное сознание.
Выше описаны основные симптомы менингита. Их следует внимательно прочесть и заучить.
Как правильно диагностировать болезнь?
Когда причины возникновения менингита уже изучены, стоит рассмотреть методы его диагностики.
Чаще всего болезнь получается определить визуально путем осмотра пациента медиком. Но самым важным анализом считается изучение спинномозговой жидкости, которую берут через люмбальную пункцию. С помощью такого исследования можно выявить количество и строение клеток, показатели глюкозы и белка. Кроме того, видна бактериоскопия капли жидкости, окрашенная по Граму.
Дополнительная диагностика менингита включает в себя рентгенограмму, томографию головы, изучение глазного дна, электроэнцефалографию и анализ крови.
Принципы лечения недуга
При бактериальной разновидности менингита человека следует незамедлительно госпитализировать. Здесь медики используют комплексную терапию: лечение менингита большими дозами антибиотиков, кортикостероидами, снижающими воспаление. Для того, чтобы убрать судороги, можно использовать транквилизаторы. Такой менингит и его симптомы излечивают чаще.
Для людей, которые болеют менингитом вирусного происхождения, антибиотики мало эффективны. Такая болезнь проходит в умеренном темпе, излечиваясь самим организмом. Здесь нужно проводить лечение менингита так, чтобы избавить человека от болезненных симптомов.
Как ухаживать за человеком, перенесшим болезнь?
Человеку, переболевшему этим опасным заболеванием, нужен специальный уход, основанный на соблюдении диеты, расписания дня и допустимых физических нагрузок.
Такие люди должны есть маленькими порциями, но часто. Диета нацелена на снятие интоксикации, восстановление процесса переваривания пищи, нормализацию обмена веществ и баланса витаминов в организме. Нельзя употреблять жирную, жареную, соленую, кислую пищу и сладости. Пить разрешено воду, чай, кефир, шиповник и компот.
Человеку важно избегать чрезмерных физических нагрузок, стрессов и волнений, больше времени проводить в постели. Разрешены ванны с теплой водой и массаж.
Отдельное время следует уделять специальной лечебной гимнастике. Пациенту нужно разминать все группы мышц, а иногда и учиться заново ходить.
Каковы прогнозы при данном недуге?
Для того, чтобы избежать неврологических повреждений, медики должны своевременно диагностировать менингит, его причины и симптомы, ведь именно ранняя диагностика дает возможность предотвратить негативные последствия менингита и полностью его излечить.
Вирусный менингит и его признаки не так опасны, ибо симптомы исчезают через пару недель без каких-либо тяжелых осложнений. Этот вид болезни обычно не повторяется, но во всем случаются исключения.
Менингит и его последствия: серьезное повреждение мозга, скопление жидкости у черепа и мозга, ухудшение слуха и зрения, эпилепсия, скачки давления, гидроцефалия.
Существует ли профилактика заболевания?
С мнением о том, что самым действенным лечением является его минимум, спорить тяжело. Чтобы постараться избежать проявлений болезни и предотвратить последствия менингита, стоит придерживаться некоторых простых правил:
- Тщательно мыть руки перед приемом пищи.
- Есть из личной посуды.
- Не пить воду из одной емкости с несколькими людьми.
- Обрабатывать тело специальными кремами и спреями от комаров.
- Забыть о вредных привычках.
- Правильно питаться.
- Побольше отдыхать.
- Принимать витамины.
- Не пытаться лечиться в домашних условиях.
- При проявлении менингита и его видов сразу же обращаться за квалифицированной помощью специалистов.

Стоит помнить о том, что ни одна болезнь так неопасна, как менингит, профилактика здесь играет большую роль. Симптомы и лечение тоже достаточно важны, поэтому следует отнестись к проблеме со всей серьезностью.
Главной мерой профилактики медики называют прививку от менингита: лечение после вакцинации требуется очень редко. Прививку можно делать, начиная с 3-х месяцев, но чаще всего ее ставят детям до 5-ти лет.
Выше рассказано о том, как выявить, диагностировать и как лечить менингит. Рекомендуется не забывать, что при первых же его симптомах нужно сразу вызывать скорую помощь или посетить участкового терапевта.
Вопрос-ответ
Как проявляются первые признаки менингита?
Менингит — опасное заболевание, которое характеризуется воспалением оболочек мозга. Болезнь, как правило, развивается стремительно, проявляется головными болями, тошнотой, рвотой, общей слабостью. В тяжёлых случаях сопровождается расстройством сознания, временными нарушениями зрения, речи и движений.
Как начинают болеть менингитом?
Менингит обычно начинается с симптомов, схожих с гриппом, таких как высокая температура, головная боль, рвота, чувствительность к свету и общая слабость. У некоторых людей могут возникать судороги и изменения в сознании. Важно сразу обратиться к врачу при подозрении на менингит, так как это состояние требует неотложной медицинской помощи.
Где болит при менингите?
При менингите боль возникает во всей голове с акцентом на шейно-затылочную область. Особая примета – трудно согнуть шею. Головную боль могут сопровождать тошнота, рвота, непереносимость яркого света.
Как проверить, что нет менингита?
Медицинский осмотр для выявления симптомов менингита, анализ крови, чтобы проверить наличие бактерий или вирусов, поясничная пункция, когда образец жидкости берется из спинного мозга и проверяется на бактерии или вирусы, КТ или МРТ головного мозга, чтобы проверить наличие отека головного мозга.
Советы
СОВЕТ №1
Обратите внимание на ранние симптомы. Менингит может проявляться такими признаками, как высокая температура, головная боль, рвота и чувствительность к свету. Если вы или кто-то из ваших близких испытывает эти симптомы, не откладывайте визит к врачу.
СОВЕТ №2
Следите за изменениями в состоянии. Менингит может развиваться быстро, поэтому важно отслеживать любые изменения в симптомах. Если состояние ухудшается или появляются новые симптомы, такие как судороги или потеря сознания, немедленно вызывайте скорую помощь.
СОВЕТ №3
Не игнорируйте симптомы у детей. У маленьких детей менингит может проявляться иначе. Обратите внимание на такие признаки, как повышенная раздражительность, отказ от еды или питья, а также необычная сонливость. В таких случаях также следует обратиться к врачу.
СОВЕТ №4
Заботьтесь о профилактике. Вакцинация против менингита может значительно снизить риск заболевания. Убедитесь, что вы и ваши дети получили все необходимые прививки, особенно в подростковом возрасте и перед поездками в регионы с высоким риском.